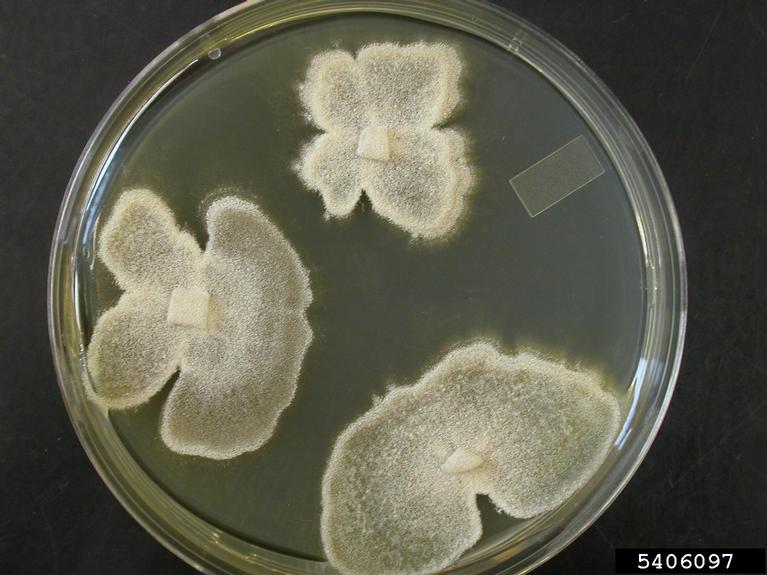

Image Number: 5406097
Photographer:
Organization:
Descriptor:
Culture
Description:
Sporulating Geosmithia in PDA agar.
Image type:
Laboratory
You must attribute the work in the manner specified (but not in any way that suggests endorsement).
Image location:
Subject
| Kingdom: Fungi |
| Phylum: Ascomycota |
| Subphylum: Pezizomycotina |
| Class: Sordariomycetes |
| Subclass: Hypocreomycetidae |
| Order: Hypocreales |
| Family: Incertae sedis |
| Genus: Geosmithia |
| Subject: Geosmithia morbida (Proposed name) |
Host
There is no applicable taxonomy of higher classification for this subject.
Node Affiliation:
Image uploaded:
Tuesday, November 24, 2009
Image last updated:
Monday, March 15, 2010